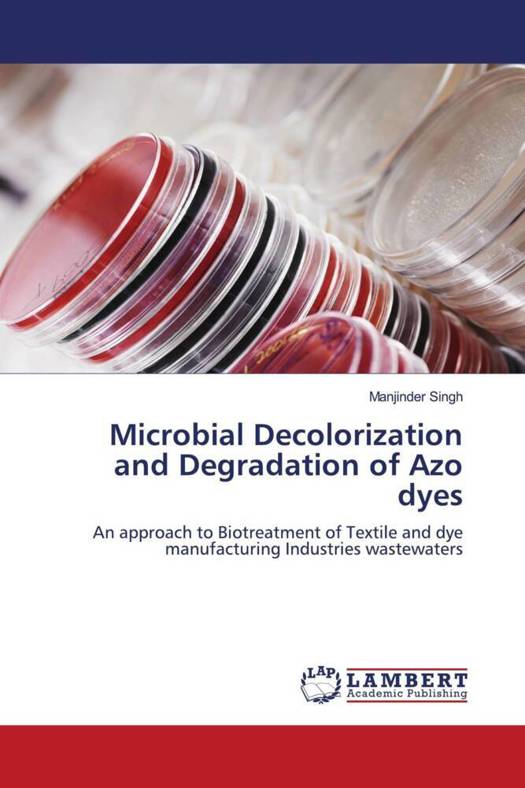

- Afhalen na 1 uur in een winkel met voorraad
- Gratis thuislevering in België vanaf € 30
- Ruim aanbod met 7 miljoen producten
- Afhalen na 1 uur in een winkel met voorraad
- Gratis thuislevering in België vanaf € 30
- Ruim aanbod met 7 miljoen producten
Zoeken
Microbial Decolorization and Degradation of Azo dyes
An approach to Biotreatment of Textile and dye manufacturing Industries wastewaters
Manjinder Singh
Paperback | Engels
€ 67,45
+ 134 punten
Omschrijving
The textile processing industries produce huge quantities of colored effluents containing significant amount of unreacted dyes. These dyes are xenobiotic in nature and are thus of environmental concern. Most of the physico-chemical methods used for dye removal are cost intensive and have limited versatility. Alternatively, biological treatment methods hold promise as relatively inexpensive way to remove dyes from wastewater. This book discussed the results of the successful implementation of biological treatment process for degradation of azo dyes. An efficient microbial inoculum was developed having wide versatility to work under both anoxic and aerobic conditions and surviving the shock loading concentrations of azo dyes and their metabolic intermediates. A sequential anoxic-aerobic bioreactor was developed using enriched consortium for the continuous treatment of synthetic textile industry wastewater. The intermediates and final products after treatment of azo dyes with bioreactor were characterized. The toxic potential of the selected azo dyes and their degradation products was assessed for the validation of treatment process.
Specificaties
Betrokkenen
- Auteur(s):
- Uitgeverij:
Inhoud
- Aantal bladzijden:
- 184
- Taal:
- Engels
Eigenschappen
- Productcode (EAN):
- 9783843378895
- Uitvoering:
- Paperback
- Afmetingen:
- 150 mm x 220 mm

Alleen bij Standaard Boekhandel
+ 134 punten op je klantenkaart van Standaard Boekhandel
Beoordelingen
We publiceren alleen reviews die voldoen aan de voorwaarden voor reviews. Bekijk onze voorwaarden voor reviews.